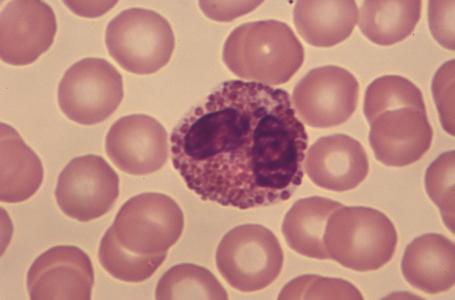
过敏性鼻炎的一般化治疗，光是确诊就需要这四个步骤，缺一不可！

秋风的凉意带来的不是一番的舒爽,而是风中卷动着的过敏原“疯狂”的“扑”向人们的鼻子,拥有过敏性体质脆弱的人群扛不住这突然“袭击”而沦陷了。这是秋天对过敏性鼻炎呼唤的最真实的“写意”。

我觉得我是一个很“残忍”的人,每次都要打断我的过敏性鼻炎的患者对于“治愈”两字的希冀,只谈“预防”,不要谈“治愈”,我觉得那对于患者来讲是一个痛苦的过程。就像是你身体的阑尾炎,只有当它发作的时候,你才迫不得已将其切除,过敏性鼻炎同样也是如此,由于过敏性鼻炎患者自身体质的缺陷,就像我前面所讲,你的“体质”为根,就算是用尽一些治疗手段,如果解决不了你体质的问题,那么总有一天,你身体的各种过敏症状还是会卷土重来的。

有些人就是有这种强迫症,非要将身体内的所有病症消除殆尽了,才会消停一会儿。这种“完美主义”者,其漫漫人生路注定是一番艰辛曲折的,无法理解“及时行乐”的真正意义。
谈过敏性鼻炎,许多人都将注意力放在“治疗”这一块,而忽略其诊断,因此这也是经常将其与“感冒”混淆的根源性所在。一般来说,一个自认为有过敏性鼻炎的患者到我这边诊断的时候会经历这四个步骤:

1、寻因
询问患者家中是否也存在有过敏性鼻炎的患者,不排除有家中遗传的可能性;询问患者是否有过敏性体质,前两点并不能确认其病症必定为过敏性鼻炎;直到第三点,询问过敏原接触的可能性,才勉强确认过敏性鼻炎的存在。

2、望诊
其一,是否同时并存有喷嚏、鼻痒、鼻塞、和流清水涕这四大症状;其二,喷嚏以清晨刚睡醒时最为严重,且鼻痒之时,喷嚏接连不断,一连可至十多个,严重者甚至是几十个,随后开始有大量的清水样鼻涕的流出,之后会伴有鼻塞、头晕、头痛的症状。需要记住的是,这些症状是有顺序性的。其三,这些症状的基础是过敏性体质。

3、检查
①鼻内镜下:鼻粘膜苍白、充血或是呈现浅蓝色,鼻甲水肿,鼻道及鼻腔之内可见清涕或是粘稠涕;
②发作期间的鼻腔分泌物涂片:可见嗜酸性白细胞较之正常之前明显的增多。
③鼻粘膜激发试验(其多针对于常年性的并且对花粉过敏者居多)。
需要注意的一点是:首者为主,后两者为辅。目的是使第一者的理论依据“站稳脚跟”。
4、理论性排除
为了使得检查的结果更具有精确性,加上其他鼻科疾病影响的可能性,所以必须要做到以下的排出:
①鼻内窥镜检查排除鼻中隔偏曲或是鼻甲肥大:患者鼻塞常年存在,且多为单侧性,并无鼻痒的症状以及季节性的发作倾向。
②通过中医诊断四步骤中的“问”,排除药物性鼻炎的可能性:多是因为使用利福平及其他多种制剂、神经节阻滞药、口服避孕药,引起鼻塞和鼻内分泌物增多的药物。

③患者是否常年伴发鼻息肉?是否伴有感染性哮喘?是否在使用过抗组胺药物之后效果极低?是否在用过色甘酸钠或是脱敏治疗丝毫无效?如果上述的所有症状的回答为“是”,那说明这是慢性鼻炎。
④嗅觉减退明显,脓性涕不断的增多,没有停止的趋势,鼻塞之时会伴有阵发性的头痛,没有这些症状的干扰,可以排除为鼻窦炎。
以上四种鼻科疾病最容易与过敏性鼻炎混淆。
这就是我对每位不确定的过敏性鼻炎患者的诊断“四步走”,缺一不可,环环相扣。而所谓的过敏原的检测并不能说明你的症状必定是过敏性鼻炎,那只能说明你有患上过敏性鼻炎的可能性,或许隐藏在你体内的“*弹炸**”还没“引燃”。

药物“对症”!
一般来说,我会给患者开三种类型的药物,分别是主药(抗过敏药)、辅药(对症处理)、关联用药(改善体质、增强抵抗力)。
主药(口服)包括鼻炎康片、通窍鼻炎片、扑尔敏、氯雷他定等等;辅药(喷鼻剂)如:通鼻炎水、呋麻滴鼻液(鼻黏膜损伤者禁用);关联用药如:葡萄籽软胶囊、氨基酸胶囊、维生素C片等等。

需要注意的是,像呋麻滴鼻液、盐酸羟甲唑啉滴鼻水滴药过频很容易导致“反跳性”鼻充血,应该严格控制其用量,按照其推荐用量为最佳。
呋麻滴鼻液、盐酸羟甲唑啉滴鼻水滴药过频易致反跳性鼻充血,应严格按推荐用量使用。
